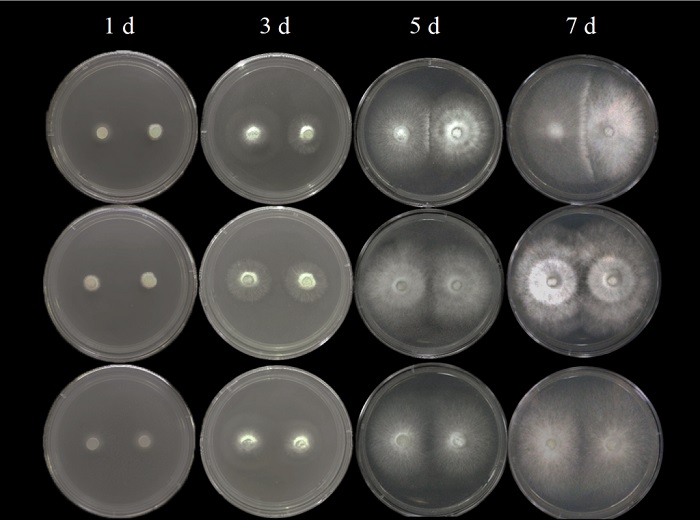

数据资源:林科动态
森环森保所筛选出高效抑制松材线虫的复合木腐菌

标题森环森保所筛选出高效抑制松材线虫的复合木腐菌
日期20251208
年份2025
学科分类 220.3010;森林病理学
内容 松材线虫病一种是由松材线虫引起的重大林木病害,具有难防难治的特点。病死木伐桩作为其传染源之一,具有防治的必要。同时,物理和化学的防治方式皆各有利弊,生物防治则因高效可持续的特点成为了主要的防治手段。
木腐菌作为一类可降解木质素和纤维素的真菌,在伐桩的处理方面具有一定潜力。有研究通过使用由单一木腐菌制成的菌剂,实现了对伐桩的有效防控。亦有诸多研究结果表明,因白腐菌降解木质素和褐腐菌降解纤维素的特点,将二者进行复合培养能够有效提高相关酶水解效率。因此,本研究立足于木腐菌的降解特性,创新性地将二者进行复合培养应用于伐桩的处理上,不仅有效降低了松材线虫病二次传播的风险,更加速了伐桩的分解,促进了林地的养分循环。
研究首先进行了白腐菌与褐腐菌的拮抗测定,筛选出不具有明显抑制作用的组合。在此基础上,进行了平板上松材线虫死亡率的测定,确定了木腐菌组合对松材线虫的致死作用。同时,根据对红松和马尾松木块降解率的测定和红外光谱观测分析,明确了木腐菌组会对木质素、纤维素和半纤维素的降解作用。最终将筛选获得的木腐菌组合制成菌剂进行应用,并获得了良好效果。
该研究以“高效抑制松材线虫的复合木腐菌筛选”为题,于2025年11月发表在《林业科学》。森环森保所原燕枝硕士为论文第一作者,王曦茁研究员为通讯作者。该研究得到了国家重点研发计划专项(2021YFD1400905)的资助。(原燕枝 王曦茁)
中国林科院 2025-12-05
资料来源中国林科院
访问热度
- 3683
- 2851
- 2635
- 2620
- 2452
- 2450
- 2445
- 2433
- 2210
- 2053
- 1941
- 1865
- 1842
- 1792
- 1786
- 1649
- 1581
- 1559
- 1508
- 1497


 打印
打印